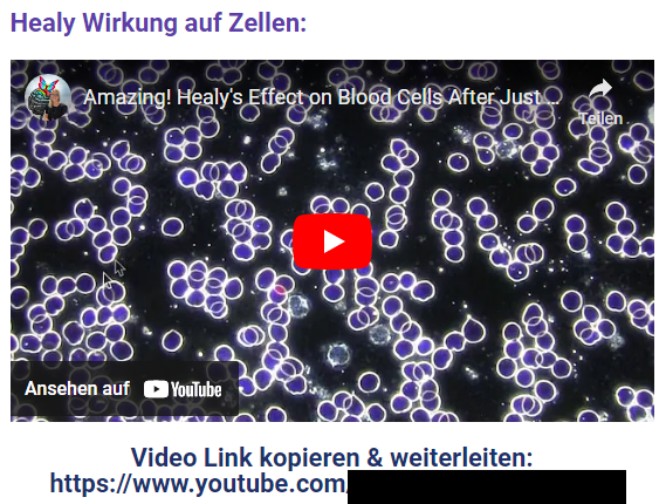

Datei:Healy Geldrollenbildung.jpg
Zur Navigation springen
Zur Suche springen
Healy_Geldrollenbildung.jpg (666 × 504 Pixel, Dateigröße: 110 KB, MIME-Typ: image/jpeg)
Dateiversionen
Klicke auf einen Zeitpunkt, um diese Version zu laden.
| Version vom | Vorschaubild | Maße | Benutzer | Kommentar | |
|---|---|---|---|---|---|
| aktuell | 00:53, 22. Okt. 2022 | 666 × 504 (110 KB) | Fulgor (Diskussion | Beiträge) |
Du kannst diese Datei nicht überschreiben.
Dateiverwendung
Die folgende Seite verwendet diese Datei: